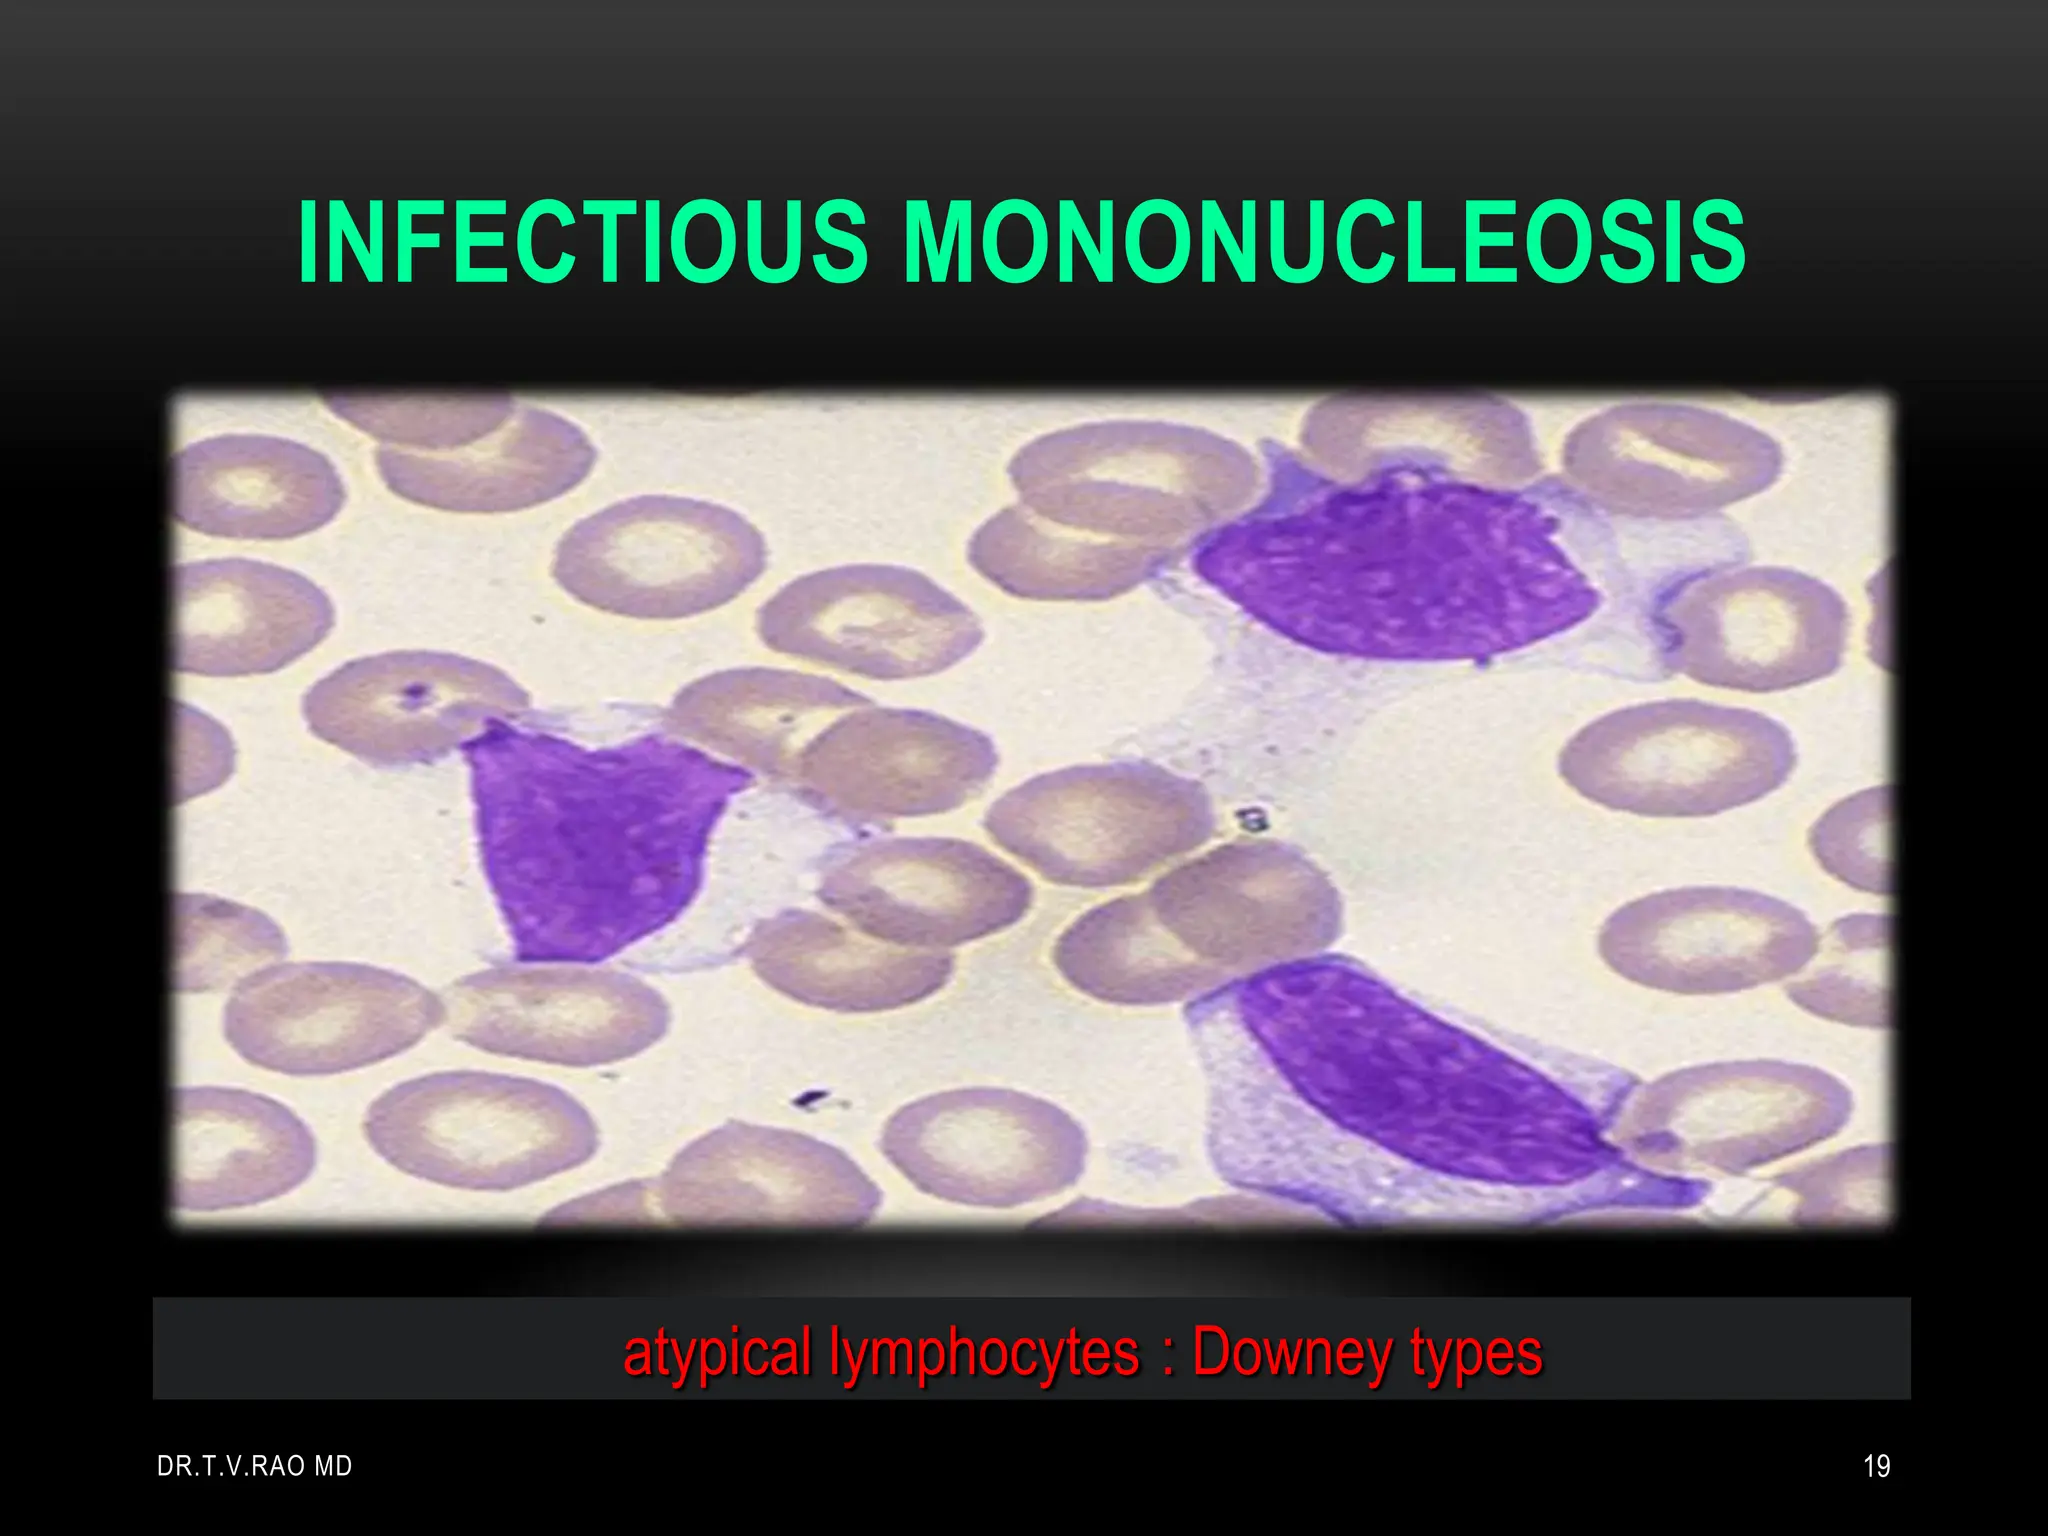
INFECTIOUS MONONUCLEOSIS
atypical lymphocytes : Downey types
DR.T.V.RAO MD 19

Embed presentation
Download as PDF, PPTX
















































1. Epstein-Barr virus (EBV) is a human herpesvirus that can establish lifelong latent infections in B cells. EBV is associated with several cancers and diseases including Burkitt's lymphoma, Hodgkin's disease, nasopharyngeal carcinoma, and infectious mononucleosis. 2. The document discusses the history and discovery of EBV and the diseases it causes. It describes infectious mononucleosis caused by primary EBV infection and provides details on its symptoms, diagnosis using heterophile antibodies, and typical laboratory findings. 3. Burkitt's lymphoma and nasopharyngeal carcinoma are also covered, noting their association with EBV and key characteristics. Molecular details of EBV replication and